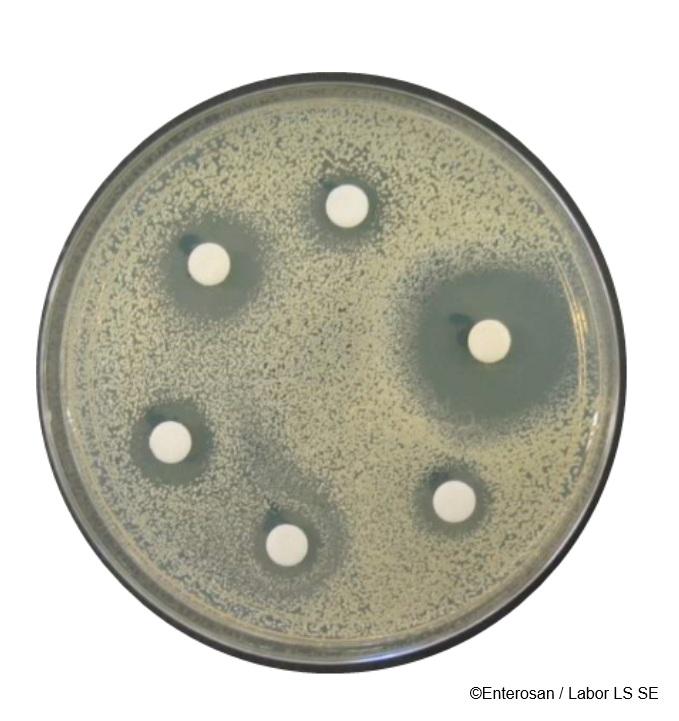

Seit etlichen Jahren stellen rezidivierende Harnwegsinfekte einen Schwerpunkt meiner Diagnostik sowie Therapie dar. Betroffene Frauen kommen teils frustriert, leider auch verzweifelt in meine Praxis. Die Erfahrung zeigt: Je öfter ihre Infekte auftreten, umso weniger werden sie in der hektischen Alltagsmedizin ernst genommen. Nach dem ersten Antibiotikum aus der Hausarztpraxis begeben sich die Patientinnen auf Odysseen durch diverse Facharztpraxen, bevor sie in der Naturheilkunde einen Hafen finden, wo sie als Mensch wieder in den Mittelpunkt gerückt werden. Das Thema der wiederkehrenden Harnwegsinfekte ist sehr komplex und kann in diesem Artikel nur mit einigen Schlaglichtern erläutert werden.
URSACHEN
Geschlechtsspezifische Anatomie Frauen sind aufgrund ihrer Anatomie deutlich anfälliger für Harnwegsinfekte, als Männer. Zum einen haben sie eine viel kürzere Harnröhre (ca. 3-4 cm im Gegensatz zum männlichen Pendant mit ca. 20 cm). Zum anderen birgt die Nähe zum After die permanente Gefahr der Keimverschleppung. Auch wenn es sich anfangs eher lustig anhört, ist die Wischrichtung auf der Toilette ein Punkt, über den man reden sollte. Eine Anamnese der Sexualpraktiken gehört in diesem Zusammenhang ebenso dazu. Um es kurz zu machen: Von vorne nach hinten – kein Problem. Von hinten nach vorne – No Go (wenn kein Kondom verwendet oder gewechselt wurde).
Antibiosen und Darmgesundheit
Eine unterschätzte Ursache sind häufige Antibiosen, welche die Patientinnen durchlaufen haben und regelmäßig zu unzureichender Wirkung oder Resistenzen führen. Darüber hinaus kann die Schleimhautabwehr aufgrund der beeinträchtigten Darmflora immer weniger leisten.
Hormonsystem
Das sehr komplexe Hormonsystem der Damenwelt macht das Thema der Schleimhautgesundheit nicht einfacher.
Schwimmbäder
Schwimmbadbesuche sind bekannte Auslöser für Infekte. Zum einen sind Verunreinigungen trotz Chlorung nicht zu verhindern, aber auch Chlor selbst kann problematisch werden. Abgerundet wird das Ganze durch synthetische Badekleidung, die nicht atmungsaktiv ist.
Psychische Komponente
Wenn sich während der Anamnese nicht gleich zu Beginn deutliche Hinweise auf die Psyche als Ursache ergeben – was der Fall wäre, wenn die Blasenentzündungen nach einer Trennung oder einem Todesfall begonnen haben oder immer nur unter „Stress“ auftreten – dann fokussieren wir uns zunächst auf den Urogenitaltrakt.
DIAGNOSE
Es ist erschreckend, wie oft Frauen trotz mehrfacher Infekte davon berichten, dass bislang nie eine Urinkultur angelegt wurde. Sich in der Apotheke gelegentlich Urin-Sticks zu kaufen, um den Urin selbst zu überprüfen, ist noch keiner meiner Patientinnen in den Sinn gekommen, geschweige denn, dass sie auf diese Möglichkeit hingewiesen wurden.
Urin-Sticks
Somit ist das ein erster möglicher diagnostischer Schritt: den Spontanurin in der Praxis mittels Stick zu überprüfen. Es finden sich oft am Nachmittag noch saure pH-Werte. Hier drängt sich der Verdacht von sehr geringen Trinkmengen oder hohem Konsum von Kaffee und anderen Genussmitteln auf.
Urinkultur
Die Urinkultur ist ein kostengünstiges und einfaches Mittel, den Urin genauer unter die Lupe zu nehmen. Hierbei werden im Labor die koloniebildenden Einheiten (kbE) bestimmt. Man sieht, ob und in welcher Größenordnung Erreger vorhanden sind, v. a. welche.
Antibiogramme
Unter geregelten Voraussetzungen lässt sich im Labor untersuchen, welche Antibiotika unwirksam, intermediär oder sensitiv sind. Dabei ist der rechtliche Rahmen für Heilpraktiker hinsichtlich Beauftragung und Abrechnung eng gesteckt – dessen sollte man sich bewusst sein. Sicherlich kein Standardvorgehen, aber bei häufigen Antibiosen in der Vorgeschichte mitunter hilfreich.
Vagicheck®
Aus mittlerweile über 15 Jahren Praxiserfahrung kann festgehalten werden, dass der Teufelskreis der Harnwegsinfekte nicht durchbrochen werden kann, solange der Vaginaltrakt als Erreger-Reservoir fungiert. Eines der wichtigsten Puzzlestücke in diesem Zusammenhang ist der Vagicheck®. Dieser mikrobiologische Test untersucht neben obligat und fakultativ pathogenen Keimen, die immer oder erst ab einer bestimmten Größenordnung als Infekt fungieren, Pilze und den pHWert. Während andernorts oft nur nach einem bestimmten „Bösewicht“ gefahndet wird (E.-coli-Infekt – ja oder nein?), wird hier das abgenommene Vaginalsekret an verschiedene Nährplatten angesetzt, und nach drei Tagen Bebrütung wird ausgewertet, was in welcher Größenordnung gewachsen ist. Trefferquote sowie Genauigkeit der Untersuchung sind einfach hervorragend.
Aromatogramm
Weiterhin kann ein Aromatogramm angefertigt werden. (Abb. 1) Hierbei werden die pathogenen Keime der Patientin isoliert und an eine neue Nährplatte angesetzt. Dort werden kleine Plättchen positioniert, die mit ätherischen Ölen getränkt sind. So kann, äquivalent zum Antibiogramm, genau ermittelt werden, welche ätherischen Öle gegen die individuellen Infektionen der Patientin wirken. In darauf spezialisierten Apotheken können Suppositorien angefertigt werden, die je nach Schweregrad 10 oder 20 Tage angewandt werden. Noch eine gute Nachricht: Wir müssen die Abstriche nicht selbst in der Praxis machen. Nach einer kurzen Einweisung bekommt die Patientin das Labor-Kit inklusive einer Anleitung mit nach Hause und kann die nötigen Abstriche und die pH-Messung dort selbst in Ruhe vornehmen.
Stuhldiagnostik
Je nachdem, an welchem Punkt ihrer Odyssee die Patientin steht, wenn sie zu uns in die Praxis kommt, kann ein Stuhlbefund sinnvoll sein. Je mehr Antibiosen ohne Symbioselenkung erfolgt sind, umso mehr obligat pathogene Keime finden sich. Liegt das Schleimhaut-Immunsystem erst einmal brach, wird es mit einer guten Resistenz gegenüber Infektionen schwer. In solchen Fällen stünde eine Darmsanierung an.
PSYCHISCH-VEGETATIVE FAKTOREN
Für die psycho-vegetative Diagnose ist die Anamnese wegweisend. Ein empathisches Gespräch mit gezielten, motivierenden Fragen weist den Weg. Manchmal können homöopathische Mittel oder dynamisierte Urtinkturen (z. B. Solidago) den psychischen Aspekt begleiten, oft ist eine weiterführende Diagnose sinnvoll. In unserer Praxis kommen verschiedene Verfahren zum Einsatz:
Herzratenvariabilität
Die schnellste und einfachste Methode ist die Messung der Herzratenvariabilität (HRV). Hiermit kann man binnen 5 10 Minuten herausfinden, wo die Patientin vegetativ einzuordnen ist. Allerdings ist hierfür eine Geräteanschaffung notwendig.
Labordiagnostik
Es gibt zwei Wege, labordiagnostisch zu arbeiten: Auf der invasiven Seite bieten Labore den Marker BDNF an – niedrige Werte weisen auf chronische Erschöpfung oder Depression hin. Auch Serotonin und bestimmte Aminosäuren können wichtige Hinweisgeber sein.
Speicheldiagnostik
Als nicht-invasives Verfahren kommt die Speicheldiagnostik infrage. Hier gibt die Patientin mehrmals am Tag Proben ab, über die ein Cortisol-Tagesprofil erstellt werden kann. Parallel dazu bestimmen wir das „Buddha-Hormon“ DHEA, um zu prüfen, wie die Nebenniere arbeitet. Kommen Schleimhautprobleme hinzu, können Progesteron und Östradiol ins Programm aufgenommen werden. Leider wird viel zu oft vergessen oder unterschätzt, dass Progesteron eine Vorstufe des „Stresshormons“ Cortisol ist und dass Stress jeglicher Art, gerade wenn er chronifiziert, zu diversen hormonellen Ungleichgewichten führen kann.
NATURHEILKUNDLICHE BEHANDLUNGSZUGÄNGE
In der Naturheilkunde können wir auf einen wahren Schatz an Therapeutika zugreifen. Zur Behandlung des Vaginaltrakts stehen uns zunächst die o.g. aromatherapeutischen Suppositorien zur Verfügung, die durch andere lokal wirksame Präparate (Zäpfchen mit Milchsäure, Probiotika, Vitamine C oder D) ergänzt werden können. Ist auch der äußere Scham-bereich betroffen, kann man z. B. mit dem Dr. Iphöfer Intimgel lindernd und pflegend unterstützen.
Phythotherapie
Auch bei Infekten der Blase selbst stehen uns etliche Strategien offen. Mit phytotherapeutischen Präparaten, die Meerrettichwurzel und Kapuzinerkresse (z. B. Angocin Anti-Infekt) oder standardisierte Extrakte aus Bärentraubenblättern enthalten (z. B. Cystinol akut, Uvalysat, Aqualibra), können wir relevante Mengen antibiotisch wirksamer Stoffe in die Blase einleiten. Allein mit einem guten Mix aus pflanzlichen Mitteln, früh eingesetzt, sind viele Harnwegsinfekte ohne Antibiotika in den Griff zu bekommen, zumindest im Lauf der Zeit. Weitere Helfer aus der Heilpflanzenwelt, welche die Durchspülungstherapie unterstützen, sind v. a. Hauhechelwurzel, Goldrute, Brennnessel, Birke und Ackerschachtelhalm. Sie erhöhen die Harnmenge deutlich und helfen, die Bakterien schneller aus der Blase zu spülen. Letztlich gibt es noch die „Anti-Haft-Fraktion“: Präparate aus Cranberry oder Preiselbeere sowie mit der Zuckerverbindung D-Mannose, die häufig kombiniert angeboten werden.
Homöopathie
An homöopathischen Mitteln gibt es mit Metasolitharis ein gutes Nierenfunktionsmittel zur oralen Einnahme, und mit Metasolidago ein Injektionspräparat, das je nach Philosophie in Reflexzonen, Dermatome, in lokaler Nähe zur Blase oder in Akupunkturpunkte injiziert werden kann. Dreluso hat mit Uroselect und Urofossat ebenfalls zwei Präparate, die den Symptomkomplex der Harnblase adressieren.
Lokale Auflagen
Ätherische Öle von Eukalyptus sowie Lavendel schaffen bei Harnverhalt, der sich im Lauf der Zeit einstellt, oft Linderung.
Mikronährstoffe
Mikronährstoffe spielen eine sehr wichtige Rolle in Prophylaxe und Therapie; hierauf näher einzugehen, würde an dieser Stelle aber den Rahmen sprengen.

Medizin der Erde - Phytotherapie – Grundlagen
- Praxisnahes Wissen zur Heilpflanzenkunde
- Fundierte theoretische Grundlagen der Phytotherapie
- Unterricht durch erfahrene Experten

Medizin der Erde – Phytotherapie – Aufbaukurs
- Vertiefen Sie Ihr Wissen über Heilpflanzen
- Wissenschaftlich und praxisnah lernen
- Erweitern Sie Ihre Anwendungskompetenz für die Praxis

Klassische Homöopathie
- Ganzheitliches Verständnis von Körper, Geist und Seele
- Fundiertes Wissen von anerkannten Dozenten
- Stark praxisorientiert für Ihren beruflichen Alltag

Aromatherapie Fachausbildung
- Ganzheitliches Wissen zu ätherischen Ölen
- Lernen Sie von erfahrenen Fachdozenten
- Vielfältige berufliche Einsatzmöglichkeiten
GANZHEITLICHER BLICK
Da ich bei vielen „alten Hasen“ lernen durfte, kann ich dazu ermuntern, die tradierten Verfahren aufrechtzuerhalten und anzuwenden. Schröpfen im Nierenbereich (BWS/LWS), Injektionen in diesen Regionen, entlang des Schambeinknochens oder in Akupunkturpunkte sowie die Akupunktur selbst haben sich begleitend sehr gut bewährt. Der Patientin signalisiert man damit, dass man nicht nur eine Blasenentzündung behandelt, sondern sie und ihre Beschwerden ernst und sich die Zeit nimmt, das Ganze zu therapieren.
Von der konkreten Symptomatik abgesehen, sind Behandlungen in der Praxis Chancen und Angebote, immer wieder mit den Patientinnen ins Gespräch zu kommen. Nicht selten ergeben sich viele Anhaltspunkte und erklärende Ergänzungen, die im Rahmen der Anamnese noch gar nicht im Fokus standen. Ebenso kann man immer wieder nachfragen, wie es mit der Intimhygiene steht, wie es sich nach dem Geschlechtsverkehr oder der Periode verhält usw.

FAZIT
Letztlich ist die ganzheitliche Sichtweise auf das Thema Urogenitaltrakt, aber auch auf die Patientin als Frau und Mensch in vielen Fällen der Schlüssel, um den Teufelskreis aus Antibiosen, Blasenspiegelungen & Co. zu durchbrechen. Wir Heilpraktiker müssen uns mit unseren Mitteln und Möglichkeiten keinesfalls verstecken. Wir können für unsere Patientinnen aus dem vollen Spektrum der Naturheilkunde sch.pfen – von Gespr.chen und Atemtherapie über Phytotherapie, Aromatherapie und Homöopathie bis hin zu tradierten Verfahren (z. B. Injektionen, Schröpfen, Akupunktur) – sie damit sehr gut abholen und empathisch begleiten. Abschließend möchte ich betonen, dass allgemein, aber auch in diesem speziellen Bereich eine engere interdisziplin.re Zusammenarbeit zwischen Schulmedizin und Naturheilkunde mehr als wünschenswert w.re. Aus meiner 20-jährigen Erfahrung heraus muss ich leider immer noch feststellen, dass das große Potenzial einer konstruktiven Kooperation noch viel zu selten ausgeschöpft wird.


